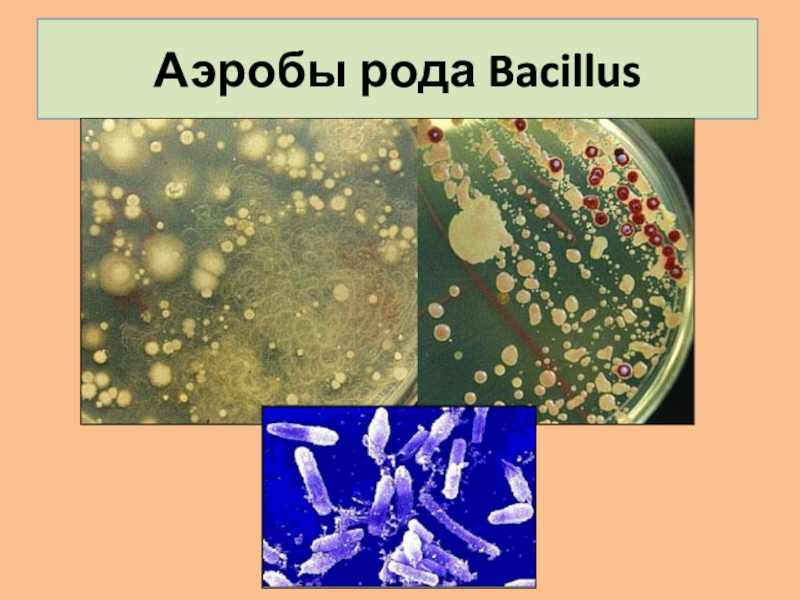

- Главная
- Разное
- Образование
- Спорт
- Естествознание
- Природоведение
- Религиоведение
- Французский язык
- Черчение
- Английский язык
- Астрономия
- Алгебра
- Биология
- География
- Геометрия
- Детские презентации
- Информатика
- История
- Литература
- Математика
- Музыка
- МХК
- Немецкий язык
- ОБЖ
- Обществознание
- Окружающий мир
- Педагогика
- Русский язык
- Технология
- Физика
- Философия
- Химия
- Шаблоны, фоны, картинки для презентаций
- Экология
- Экономика
Презентация, доклад на тему Настоящие бактерии
Содержание
- 1. Настоящие бактерии
- 2. Слайд 2
- 3. СХЕМА СТРОЕНИЯ БАКТЕРИАЛЬНОЙ КЛЕТКИ
- 4. Слайд 4
- 5. ФОРМЫ НАСТОЯЩИХ БАКТЕРИЙстрептококкиСтафилококкиспириллы
- 6. РАСПОЛОЖЕНИЕ ЖГУТИКОВ У БАКТЕРИЙ
- 7. РАЗМНОЖЕНИЕ БАКТЕРИЙ
- 8. Слайд 8
- 9. Бактерии по отношению к кислороду делятся на:Аэробов
- 10. Аэробы рода Bacillus
- 11. Роль бактерий в природе и жизни человекаРазрушители
СХЕМА СТРОЕНИЯ БАКТЕРИАЛЬНОЙ КЛЕТКИ
Слайд 9Бактерии по отношению к кислороду делятся на:
Аэробов (существуют только в кислородной
среде);
Анаэробов (существуют только в бескислородной среде).
Анаэробов (существуют только в бескислородной среде).
Слайд 11Роль бактерий в природе и жизни человека
Разрушители органического вещества;
Процесс брожения;
Симбиоз с
другими живыми организмами;
Хищничество (поедание представителей других видов прокариот);
Патогенные бактерии – источники различных заболеваний.
Хищничество (поедание представителей других видов прокариот);
Патогенные бактерии – источники различных заболеваний.